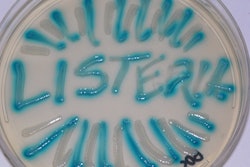

A shipment of 36 million pounds of soybeans sailed late last year from Ukraine to Turkey to California. Along the way, it underwent a remarkable transformation.
The cargo began as ordinary soybeans, according to documents obtained by The Washington Post, and like ordinary soybeans, they were fumigated with a pesticide and priced accordingly, too.
But by the time the 600-foot cargo ship carrying them to Stockton, Calif., arrived in December, the soybeans had been labeled “organic,” according to receipts, invoices and other shipping records. That switch—the addition of the “USDA Organic” designation—boosted their value by approximately $4 million, creating a windfall for at least one company in the supply chain.
To continuing read the full original article, please click here.